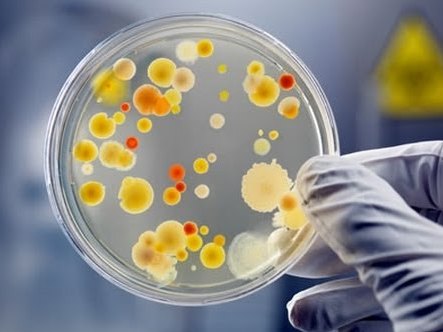

What are the key differences between gram positive and gram negative bacteria?
Gram positive bacteria remain coloured with gram staining even after washing. Gram negative bacteria do not retain their stain. Gram positive bacteria do not have an outer membrane (lipopolysaccharide and protein) Gram positive bacteria have a smooth cell wall with 70-80 percent peptidoglycan/ Gram negative bacteria have a wavy wall that comes in contact with the plasma membrane. The wall contains 10-20 percent peptidoglycan. + - No porins present - - Porins or hydrophilic channels occur in the outer membrane.

What is the gram stain appearance of gram positive bacteria?
Purple
What is the gram stain appearance of gram negative bacteria?
Red
What is the gram stain appearance of cocci?
Spherical
What is the gram stain appearance of bacilli?
Rod shaped
What can you find on the cell surface of bacteria?
Plasma membrane
Penicillin binding sites
Peptidogylcan
Lipopolysaccharides
(in gram negative bacteria)
What is the function of the murein / peptidoglycan?
Strength and shape Counteracts the high osmotic pressure of the bacterial protoplast.
What is the response to lipopolysaccharides in animals and humans?
Strong immune response
What are frimbriae and what is the function?
A series of thread like projections used for adherence

What are spores?

Highly resistant dominant structures. A unit of asexual reproduction - Used in unfavourable conditions
How do bacteria replicate?
Binary fission - identical progeny
How is genetic variation increased in bacteria?
Spontaneous mutation
Transfer of DNA
What is a bacteriophage?
A virus which parasitizes a bacterium by infecting it and reproducing inside it.
How do you see an individually cultured bacteria?
Microscope Stain
How do you view a colony of individual bacteria?
Seen by eye, they are cultured on solid medium (agar)
A bacteria name is the combination of the genus and the species. What is the difference?
The genus name forms the first part of the name for each species within the genus.
What is used to identify strains within a species?
DNA typing techniques
